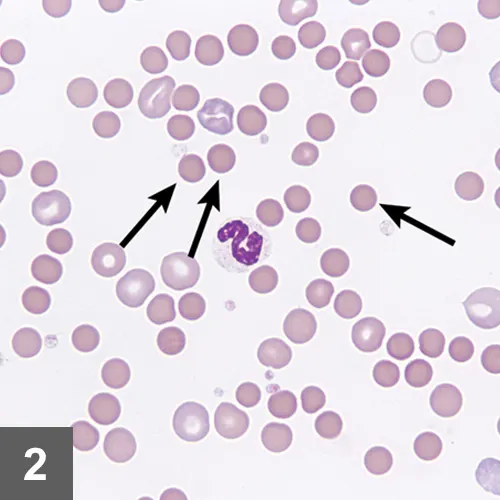
Featured Image

Rare Autoimmune Disease in a Dog
Jean-Sébastien Palerme, DVM MSc, DACVIM (SAIM), Iowa State University

Spike, a 6-year-old castrated crossbreed dog, was presented for a 2-day history of lethargy.
History
The clients reported that before this period, Spike had been healthy. He was up-to-date on core vaccines and had received his last vaccines 1 month before presentation. In addition, he receives monthly heartworm and flea preventives. The clients reported that they recently noted some of Spike’s stool seemed darker in appearance. The owners reported no possible exposure to rodenticides.
Physical Examination
Spike was quiet, alert, and responsive on presentation. Thoracic auscultation revealed tachycardia (heart rate, 150 bpm) with a grade II/VI left systolic heart murmur and bounding femoral pulses. Oral mucous membranes were pale pink and had numerous petechiae (Figure 1A). Ecchymoses were noted on his abdomen (Figure 1B). Rectal temperature was increased (103.2° F). Melena was noted on rectal examination.


On examination, petechiae were present on the gingival mucosae (A) and large ecchymoses were present on the abdomen (B).
General Practice Skill: Create a Problem List
Generate an initial problem list based only on patient history and physical examination results as described above.
Being an excellent veterinary diagnostician depends on a solid foundation in the basics. Explore more problem list challenges in our General Practice Skills series here.
Laboratory Diagnostics
CBC results indicated a regenerative anemia, thrombocytopenia, and an inflammatory leukogram (Significant Laboratory Results, below). Spherocytosis was noted on review of a blood smear (Figure 2).
Marked spherocytosis noted on review of blood smear. Image courtesy of Dr. Jennifer Neel, North Carolina State University
A slide agglutination test was performed by mixing a drop of blood with a drop of saline on a glass slide and observing for clumping. The test was positive, suggesting the presence of antibodies on the surface of the red blood cells. Chemistry profile revealed hyperbilirubinemia and increased blood urea nitrogen, alkaline phosphatase, and alanine aminotransferase values. All other values were within normal limits. Urinalysis revealed minimally concentrated urine with moderate bilirubinuria.
Significant Laboratory Results
CBC
Chemistry Panel
Thoracic radiographs and abdominal ultrasound revealed no significant findings. Vector-borne disease testing, including serology and PCR for Ehrlichia spp, Babesia spp, Anaplasma spp, Rickettsia spp, and Bartonella spp was negative. Prothrombin and activated partial thromboplastin times were normal.
Ask Yourself
How is immune-mediated hemolytic anemia (IMHA) diagnosed?
What causes of thrombocytopenia should be considered?
How should Spike’s anemia and thrombocytopenia be treated?
Diagnosis
Concurrent primary immune-mediated hemolytic anemia and severe thrombocytopenia
Discussion
Evans syndrome is a rare autoimmune condition characterized by the concurrent presence of a primary (idiopathic) immune-mediated hemolytic anemia (IMHA) and primary immune thrombocytopenia (ITP).1 Spike was diagnosed with a primary IMHA based on the presence of a regenerative anemia with spherocytes, a positive slide agglutination test, and unremarkable ultrasonographic and radiographic findings with negative vector-borne disease testing. Although thrombocytopenia is reported in up to 70% of veterinary IMHA cases, it is usually a result of a cause other than primary immune-mediated destruction, such as vasculitis or hypercoagulability.2 Given the difficulty in proving that both cytopenias are caused by a primary immune-mediated disease, it is preferable to avoid the term Evans syndrome and instead to state that there is concurrent immune-mediated hemolytic anemia and severe thrombocytopenia.
Treatment
Spike was treated with dexamethasone at 0.14 mg/kg q12h IV and cyclosporine at 5 mg/kg q12h PO. In addition, his thrombocytopenia was specifically treated with a single vincristine injection at 0.02 mg/kg IV. Coverage for potential tick-borne infections was provided by doxycycline at 5 mg/kg q12h IV pending serology and PCR results. Based on the presence of melena and an increased blood urea nitrogen level, a possible GI bleed was treated with omeprazole at 1 mg/kg q24h PO and sucralfate at 1 g q8h PO. Because of the high incidence of thromboembolic disease in patients with IMHA,2 Spike received a platelet aggregator inhibitor (clopidogrel, 2 mg/kg q24h PO).
For initial stabilization, Spike was given a 10 mL/kg transfusion of packed RBCs. A total of 4 transfusions were necessary throughout his hospitalization to maintain cardiovascular stability.
Outcome
Spike was discharged after 6 days of hospitalization as his platelet count returned to normal (233 000/µL) and his PCV had stabilized (26%). Oral medications were continued at home with prednisone (2 mg/kg q12h), cyclosporine (5 mg/kg q12h), doxycycline (5 mg/kg q12h), omeprazole (1 mg/kg q24h), and clopidogrel (2 mg/kg q24h).
One week after discharge, Spike was more energetic. CBC results showed continued improvement of RBC and platelet values. He was subsequently rechecked every 3 to 4 weeks, including a physical examination, CBC, and chemistry panel. At 1-month posthospitalization, Spike’s platelet count and hematocrit were normal. Once CBC values were normalized for 4 consecutive weeks, immunosuppressive medications were tapered. Prednisone was initially tapered by 25% each month as long as platelet and RBC counts were stable. By 5 months after discharge, Spike’s prednisone was discontinued. Cyclosporine was discontinued after an additional month.
Ask Yourself
1. How is immune-mediated hemolytic anemia (IMHA) diagnosed?
Diagnosis of IMHA is based on the presence of anemia in combination with 1 of 3 findings: RBC autoagglutination, spherocytosis, or a positive Coombs test. In Spike’s case, both autoagglutination and spherocytosis were identified, making the diagnosis straightforward. Although 60% to 75% of canine IMHA cases are idiopathic, the presence of underlying causes such as neoplasia, tick-borne diseases, and adverse drug reactions should be investigated.3
2. What causes of thrombocytopenia should be considered?
If thrombocytopenia is identified on a CBC, a blood slide should be reviewed to rule out the presence of platelet clumping, which can artificially decrease automated counts (pseudothrombocytopenia). This also allows for estimation of the number of platelets present per microliter by using the following equation: Total platelets in 10 hpf* / 10 x 15,000
Causes of thrombocytopenia include decreased production, increased consumption (eg, blood loss), destruction, or abnormal platelet distribution/sequestration. In Spike’s case, decreased production by the bone marrow was unlikely for 2 reasons. First, the mean platelet volume was increased, suggesting the bone marrow was releasing larger, immature platelets into circulation. Second, the absence of neutropenia and the presence of a regenerative anemia is not consistent with primary bone marrow disease. Whereas blood loss can lower platelet counts acutely, the deficits are usually mild and in proportion to the degree of anemia. Given the degree of Spike’s thrombocytopenia and absence of hypoproteinemia, it was unlikely that blood loss (as noted by the presence of melena) was the only cause of his thrombocytopenia.
Platelet consumption or destruction can be more difficult to document, and the clinician should investigate the presence of an underlying cause. Spike was not receiving any medications at the time of diagnosis, and neoplasia was considered unlikely because diagnostic imaging revealed no abnormalities. Likewise, an infectious cause was thought less likely given the negative vector-borne disease testing, including both serology and PCR. Disseminated intravascular coagulation is a common cause of thrombocytopenia in critically ill patients and should be suspected in the presence of prolonged coagulation times with increased d-dimers or fibrinogen degradation products. DIC was not suspected in this case given the patient’s stable clinical condition and normal PT and aPTT values.
3. How should Spike’s anemia and thrombocytopenia be treated?
Immunosuppression is the mainstay of treatment for primary IMHA and ITP and is based on the combination of corticosteroids with a second immunosuppressive agent. Also, 2 adjunct therapies have been shown to independently decrease hospitalization time in ITP patients.4,5 Vincristine, a vinca alkaloid, is thought to act by accelerating thrombopoiesis. Bone marrow suppression is rarely seen at the doses used for ITP treatment, but care must be taken when administering the drug as phlebitis can occur with extravasation of the drug. Additionally, vincristine needs to be used with caution in collies or other breeds with MDR1 deletion. Human IV immunoglobulin (hIVIg), a more costly but effective option than vincristine,6 is thought to act by binding to the Fc receptors present on mononuclear cells. Immediate hypersensitivity reactions have been rarely reported with hIVIg administration.7
*hpf = 100x high power field